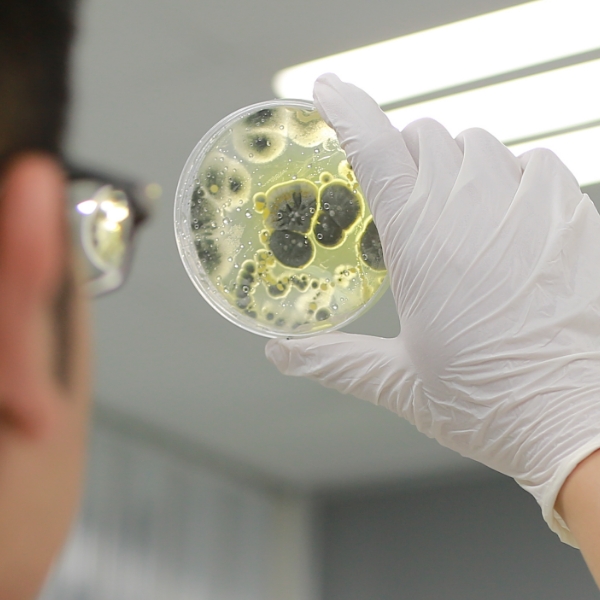
Mrc03

Streamline your mold inspection process with advanced technologies. Get precise and actionable results to maintain a safe and mold-free environment.
Our advanced mold identification technology can be utilized as a stand-alone service or integrated into our auditing processes. By quickly identifying mold species and contamination sources, this technology enhances our ability to pinpoint and mitigate mold risks, offering unparalleled insight for our partners.
MCA series services
MO series services
Smart EA
· MCA series services
Our Mold Research Center (MRC) provides a suite of specialized testing services:
MCA
Mold Characteristic Analysis
MI
Mold Identification
MRIS
Mold Relevant Issues speculation
MRIJ
Mold Relevant Issues Judgement

· Scope of application
material supplier
product manufacturer
brand
Collecting area
Mold Identification-MCA/MI
Mold time point-MRIS
Mold Relevant Issues Judgement-MRIJ
· Mold Risk Analysis & Prediction
Aim to avoid mold issues occurring without responsible agents.

· Risk Assessment for Developing Material
Risks of mold on various materials.


· Levels & Standards
Inoculate the mold spores on the samples to see the sensitivity of the material.
Four indexes related to mold risk are evaluated:
1.The lowest moldy concentration
2.Severity
3.Mold growth rate
4.Potential period
Result – Mushroom Leather (Blue)

Comment:
“The lowest moldy concentration” is the main factor of mold risk.
Little amount of mold spores attached to the sample is enough to cause the mold to spread.
· Super-Smart Mold Inspections

A powerful mold database combined with advanced technology enables three-second identification, providing clients with real-time mold information.wherever you are, the three-second identification technology delivers fast and professional mold insights, serving as a strong support for your products and environment.

Rapid identification technology and professional insights ensure that time is no longer a barrier, bridging the gap between us and the unknown. Let the three-second identification technology safeguard quality.
Application environment:
Fiber material

Metal material

Plastic material

Glass material

factory

medical environment

residential space

food manufacturing environment

